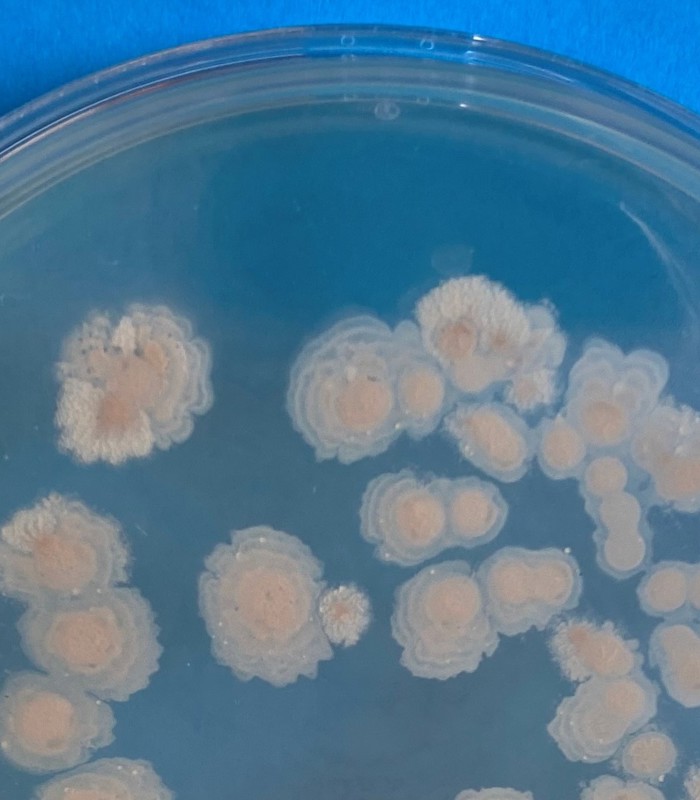
Microbiële contaminanten

Consumenten omarmen de trend om meer plantaardig voedsel in hun dieet op te nemen, wat leidt tot een sterke en gestage toename in de ontwikkeling en productie van voedingsmiddelen op basis van plantaardige eiwitten. Hoewel deze voedingsmiddelen gezonde en smakelijke alternatieven kunnen zijn voor zuivel- of vleesproducten, moeten ze ook veilig, betrouwbaar en van hoge kwaliteit zijn.
Nieuwe plantaardige ingrediënten bevatten echter vaak onbekende soorten en niveaus van microben en er is een aanzienlijk gebrek aan kennis over de risico's van deze microbiële contaminanten. Veel plantaardige eiwitten zijn afkomstig van gewassen die dicht bij de grond geoogst worden en kunnen besmet zijn met een breed scala aan organismen.
Het kan bijvoorbeeld gaan om sporenvormende bacteriën die mogelijk warmtebehandelingen kunnen overleven. Verschillende microben kunnen ook worden geïntroduceerd tijdens het oogsten en de opslag, of tijdens het verwerkingsproces van plantaardige eiwitten. Dit bemoeilijkt het ontwerp van efficiënte verwerkingsomstandigheden en veilige productformuleringen, en het uitvoeren van effectieve troubleshooting wanneer microbiologische besmetting optreedt in eindproducten.